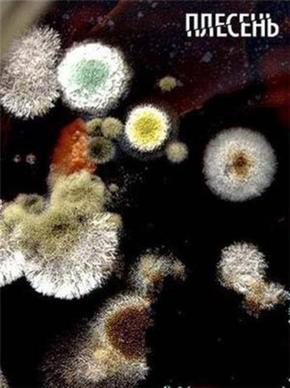
Плесень

Плесень / Плесень
“Она появилась на Земле 200 миллионов лет назад. Она убивает и спасает от смерти. Ее называют “хлебом дьявола” и “плевком Бога”. Она сказочно красива, но вызывает отвращение”, – это цитата из нового масштабного документального проекта “Плесень”, который в самое ближайшее время выйдет на Первом канале. Красочные сравнения и образы, яркие кадры, сложные компьютерные инсталляции демонстрируют зрителю отнюдь не фантастическое и невиданное существо, а то, что сопровождает человека от рождения и до смерти – плесень. Создатели картины – авторы нашумевших проектов “Осторожно, еда!” и “Великая тайна воды”. “Это была моя личная просьба, потому что я очень люблю соленые огурцы, – рассказал перед премьерой заместитель генерального директора по общественно-политическому вещанию ОАО “Первый канал” Олег Вольнов. – Я лично просил авторов ответить мне на вопрос: если на них появилась плесень, можно ли помыть огурец и его съесть? Авторы ответили: “Нельзя” При этом я лично настаивал, чтобы акцент в фильме был сделан на бытовую применимость знаний”. В фильме рассказывается о том, что плесень вездесуща, а благоприятные условия для ее размножения создает сам человек – устанавливает стеклопакеты, кондиционеры и фильтры для очистки воды.В документальном рассказе приведены мнения множества выдающихся ученых из университетов и научных институтов России, Франции, Великобритании и США. В фильме исторические факты иллюстрируют полномасштабные постановочные сцены с участием актеров.